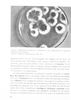

- ΙΕΠ
- Σχολικό Εγχειρίδιο
- Β' Λυκείου
Ιωάννης Θ. Παπαβασιλείου
Υγιεινή Β΄ Λυκείου
[1978]
Σχολικό εγχειρίδιο Υγιεινής για τη Β΄ Λυκείου που εστιάζει περιβαντολλογική διάσταση της υγιεινής, τα λοιμώδη νοσήματα, και την κοινωνική υγιεινή.
Εισαγωγή
5Δημογραφία
8Αέρας
22Κλίμα και καιρός
28Διαταραχές από την ιοντογόνο ακτινοβολία
32Νερό
35Φυσικά μέσα. Χημικά μέσα. Μηχανικά μέσα
39Διατροφή
52Καπνός και Κάπνισμα
69Λοιμώδη Νοσήματα
73Συνήθη λοιμώδη νοσήματα στην Ελλάδα
86Επιδημιολογία μη λοιμωδών Νόσων
105Ψυχικά νοσήματα
108Κληρονομικές και συγγενείς Νόσοι. Ευγονική
109Υγιεινή του σώματος και του πνεύματος
112Κοινωνικά νοσήματα και κοινωνική Υγιεινή
120Επαγγελματική υγειινή και Ιατρική της εργασίας
27
- ΠΕΔΙΟ ΑΝΑΓΝΩΡΙΣΗΣ »
- ΠΕΔΙΟ ΠΕΡΙΕΧΟΜΕΝΟΥ »
- ΠΕΔΙΟ ΠΛΗΡΟΦΟΡΙΩΝ ΕΚΔΟΣΗΣ »
- ΠΕΔΙΟ ΠΑΡΑΤΗΡΗΣΕΩΝ »
- ΕΥΡΕΤΗΡΙΟ ΘΕΜΑΤΙΚΩΝ ΟΡΩΝ »
| TopΠΕΔΙΟ ΑΝΑΓΝΩΡΙΣΗΣ |
|---|
Κωδικός αναγνώρισης: 01-18417 Τίτλος: Υγιεινή Β΄ Λυκείου Συγγραφέας: Ιωάννης Θ. Παπαβασιλείου Μέγεθος και υπόστρωμα: Σχολικό εγχειρίδιο, 20εκ., μαλακό εξώφυλλο, 135 σελίδες. |
| TopΠΕΔΙΟ ΠΕΡΙΕΧΟΜΕΝΟΥ |
Βαθμίδα εκπαίδευσης: Δευτεροβάθμια Τάξη: Β' Λυκείου Μάθημα: Υγιεινή Γλώσσα: Δημοτική Παρουσίαση περιεχομένου: Σχολικό εγχειρίδιο Υγιεινής για τη Β΄ Λυκείου που εστιάζει περιβαντολλογική διάσταση της υγιεινής, τα λοιμώδη νοσήματα, και την κοινωνική υγιεινή. |
| TopΠΕΔΙΟ ΠΛΗΡΟΦΟΡΙΩΝ ΕΚΔΟΣΗΣ |
Εκδότης: Οργανισμός Εκδόσεως Διδακτικών Βιβλίων Έτος έκδοσης: 1978 Τόπος έκδοσης: Αθήνα Υπουργική απόφαση / Σύμβαση: 3023/25-2-1978 Έτος έγκρισης: 1978 |
| TopΠΕΔΙΟ ΠΑΡΑΤΗΡΗΣΕΩΝ |
Εντοπισμός πρωτοτύπου: Ινστιτούτο Εκπαιδευτικής Πολιτικής Κωδικός βιβλιοθήκης: 18417 |
| TopΕΥΡΕΤΗΡΙΟ ΘΕΜΑΤΙΚΩΝ ΟΡΩΝ |
Σχετιζόμενα πρόσωπα: Σχετιζόμενοι όροι: |
LDR 01110 2200205 4500
035 ## _a01-18417
040 ## _aΙνστιτούτο Εκπαιδευτικής Πολιτικής
041 ## _ael
100 ## _aΙωάννης Θ. Παπαβασιλείου
110 ## _a18417
245 0# _aΥγιεινή Β΄ Λυκείου
260 ## _aΑθήνα
_bΟργανισμός Εκδόσεως Διδακτικών Βιβλίων
_c1978
300 ## _a135
_c20
520 ## _aΣχολικό εγχειρίδιο Υγιεινής για τη Β΄ Λυκείου που εστιάζει περιβαντολλογική διάσταση της υγιεινής, τα λοιμώδη νοσήματα, και την κοινωνική υγιεινή.
521 ## _aΒ' Λυκείου
522 ## _aΕλλάδα
546 ## _aΔημοτική
563 ## _aΜαλακό Εξώφυλλο
583 ## _a3023/25-2-1978
_c1978
650 #4 _aΑκτινοβολία
_aΑποχέτευση
_aΑτμόσφαιρα
_aΕπιδημίες επαγγελματική και δημόσια υγιεινή
_aΙατρική της εργασίας
_aΜόλυνση